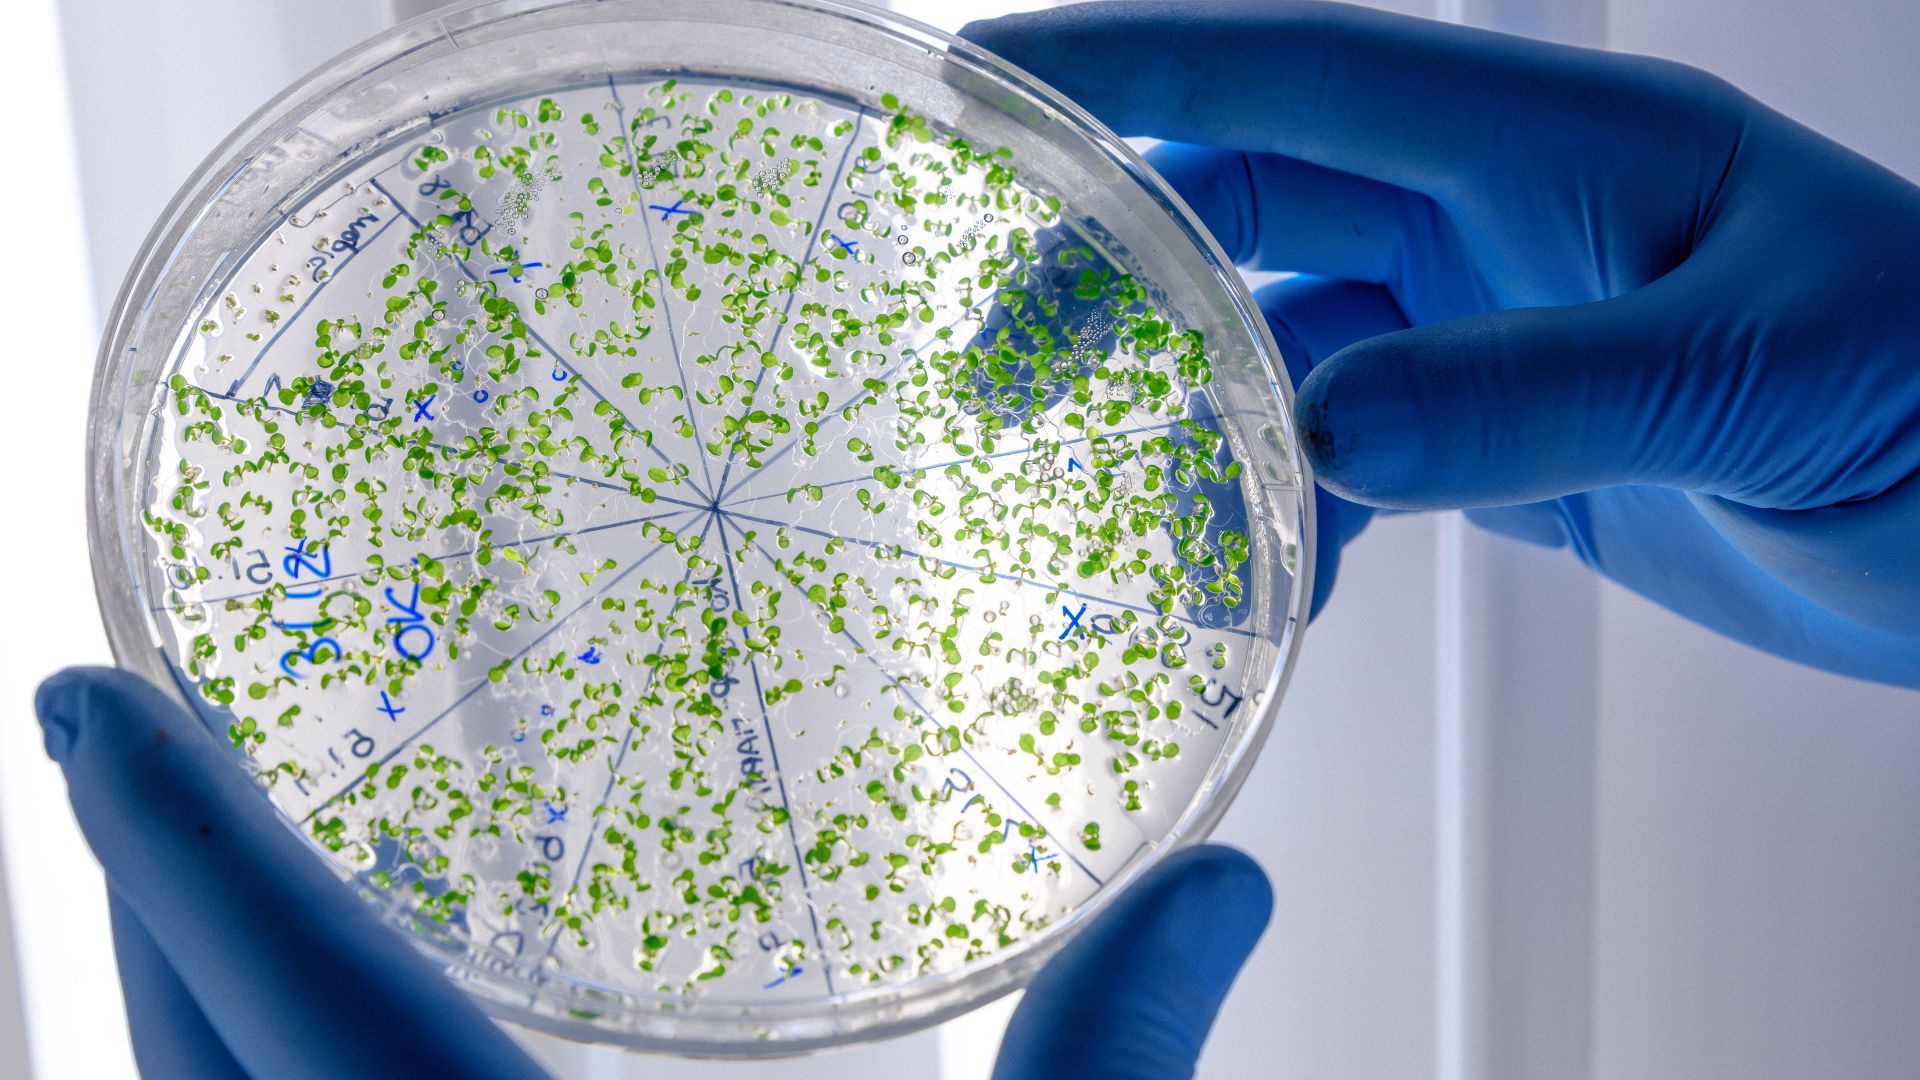
Este cuerpo podría explicar el inicio de la vida en la Tierra.

El ser humano considera que el tamaño del cerebro es un factor determinante en la inteligencia y supervivencia de la especie. Sin embargo esto, en la naturaleza es un mito, dado que la estructura corpórea, organización y conectividad neuronal es algo mucho más importante en las actividades diarias para la supervivencia que el volumen cerebral.
Esta estructura orgánica es indispensable, dado que es la que recibe estimulaciones a las cuales debe reaccionar el cuerpo para diferentes, pero la naturaleza ha demostrado que no es necesario tener un cerebro para sobrevivir en el entorno de hábitat o para ser inteligente y el argumento natural es el Stentor Coeruleus.
Stentor Coeruleus es un microorganismo de apenas 1 milímetro de tamaño, descubierto en 1744 por el suizo Abraham Trembley. Era confundido con un tipo de hidra, un microorganismo de agua; especialmente por su forma, calificada por científicos como trompetas.

¿Por qué Stentor Coeruleus ha sorprendido a los humanos?
Científicos de la Universidad de Harvard realizaron estudios con este microorganismo con el fin de saber cómo el protozoo es capaz de realizar proceso de aprendizaje asociativo, lo que se consideraba imposible en seres sin cerebros complejos. De acuerdo con PubMed Central, este cuerpo unicelular está compuesta por estructuras eucariotas complejas, que se han especializado en alimentación, locomoción y regeneración.
Tiene una composición molecular compleja que incluye proteínas, lípidos, carbohidratos y ácidos. Samuel Gershman, autor del estudio declaró que los resultados lo dejaron sorprendido: "Esto me sorprendió, porque no teníamos evidencia previa de aprendizaje asociativo en este organismo, así que no teníamos forma de saber si funcionaría".
¿Cuál fue el experimento que realizaron?
Para comprobar si este cuerpo era capaz de asociar estímulos, los científicos investigaron sobre decenas de ejemplares en dispositivos de precisión. Determinaron, gracias a los datos obtenidos, que este protozoo se habitúa al entorno que le rodea y las situaciones que enfrenta para determinar su supervivencia.
En dos momentos diferentes aplicaban impulsos eléctricos en estos cuerpos, primero un toque suave, seguido de uno más intenso un segundo después. Tras diez repeticiones de este patrón, los individuos comenzaron a protegerse, atendiendo que el primer impulso eléctrico advertía un golpe más fuerte, por lo que se contraían para evitar las consecuencias del golpe.

Para Samuel Gershman, lo anterior sugiere "que las células individuales pueden implementar algoritmos de aprendizaje no triviales", por lo que la existencia de procesos lógicos en una célula existen. Pero para los científicos esto plantea la posibilidad de que el origen de la memoria y asociación de ideas es más antiguo de lo que se creía, o por lo menos, preceden la aparición de los sistemas nerviosos centrales.
Este informe es importante, porque se determina que la inteligencia no requiere materia gris o circuitos sinápticos complejos. Al observar cómo esta estructura simple realiza una respuesta a estímulos, los científicos determinan que la plasticidad conductual es una característica de la biología celular.
Entre las conclusiones se establecer que las formas avanzadas de conocimiento pudieron haber existido antes de que la vida fuera pluricelular y que el aprendizaje asociativo no requiera de la presencia o no de un cerebro. Gershman se planeta que no hubo cerebro en otros seres antes de aprender sobre supervivencia y que la evolución de este ser puede ayudar a comprender la formación corpórea posterior.
También realizaron la comparación entre los organismos estudiados y las neuronas que componen el cerebro humano, indicando que la arquitectura de uno de los órganos más importantes para el humano usa estos mecanismos para aprender.













